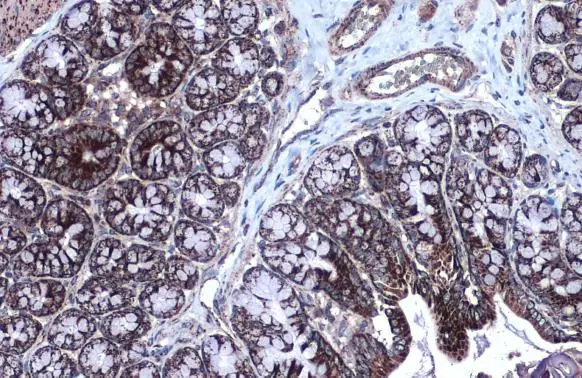
MDH2 antibody detects MDH2 protein at mitochondria by immunohistochemical analysis. Sample: Paraffin-embedded rat colon. MDH2 stained by MDH2 antibody (GTX105870) diluted at 1:500. Antigen Retrieval: Citrate buffer, pH 6.0, 15 min

Sample (20 μg of whole cell lysate) A: mouse brain 10% SDS PAGE GTX105870 diluted at 1:10000 The HRP-conjugated anti-rabbit IgG antibody (GTX213110-01) was used to detect the primary antibody.
MDH2 antibody
GTX105870
ApplicationsImmunoFluorescence, Western Blot, ImmunoCytoChemistry, ImmunoHistoChemistry, ImmunoHistoChemistry Paraffin
Product group Antibodies
ReactivityHuman, Mouse, Rat
TargetMDH2
Overview
- SupplierGeneTex
- Product NameMDH2 antibody
- Delivery Days Customer9
- Application Supplier NoteWB: 1:500-1:20000. ICC/IF: 1:100-1:1000. IHC-P: 1:100-1:1000. *Optimal dilutions/concentrations should be determined by the researcher.Not tested in other applications.
- ApplicationsImmunoFluorescence, Western Blot, ImmunoCytoChemistry, ImmunoHistoChemistry, ImmunoHistoChemistry Paraffin
- CertificationResearch Use Only
- ClonalityPolyclonal
- Concentration0.16 mg/ml
- ConjugateUnconjugated
- Gene ID4191
- Target nameMDH2
- Target descriptionmalate dehydrogenase 2
- Target synonymsDEE51, EIEE51, M-MDH, MDH, MGC:3559, MOR1, malate dehydrogenase, mitochondrial, malate dehydrogenase 2, NAD (mitochondrial), testicular tissue protein Li 120
- HostRabbit
- IsotypeIgG
- Protein IDP40926
- Protein NameMalate dehydrogenase, mitochondrial
- Scientific DescriptionMalate dehydrogenase catalyzes the reversible oxidation of malate to oxaloacetate, utilizing the NAD/NADH cofactor system in the citric acid cycle. The protein encoded by this gene is localized to the mitochondria and may play pivotal roles in the malate-aspartate shuttle that operates in the metabolic coordination between cytosol and mitochondria. [provided by RefSeq]
- ReactivityHuman, Mouse, Rat
- Storage Instruction-20°C or -80°C,2°C to 8°C
- UNSPSC41116161